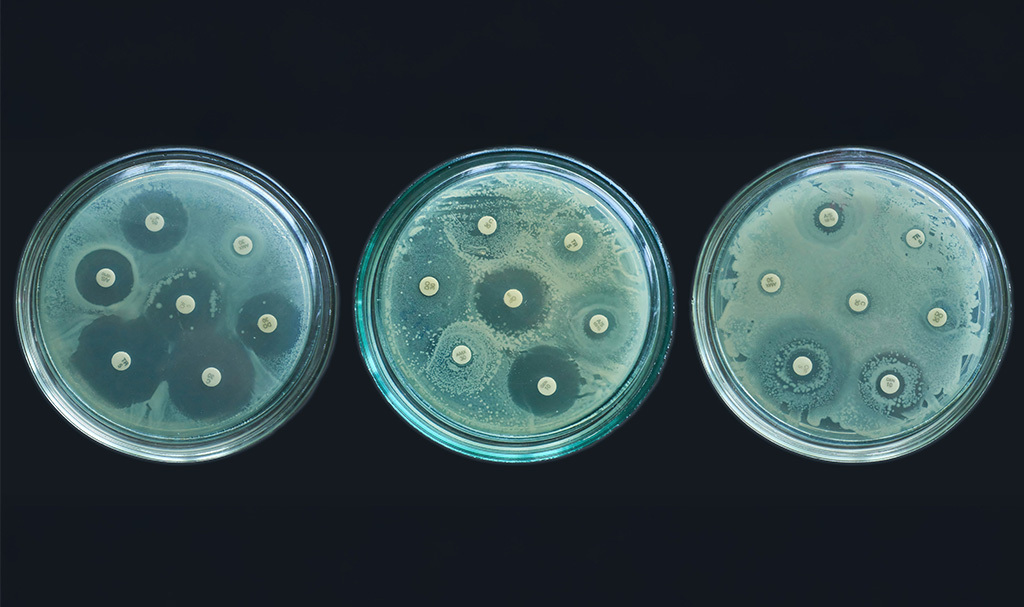

Puja Bhattacharjee
ABOUT
Puja is a multimedia journalist based in Kolkata, India. She writes about social justice, health, policy, LGBTQIA+ issues and culture.
Stories by Puja Bhattacharjee
Why High Altitudes Trigger Headaches
At the summit of Mount Fuji, researchers tracked blood flow in climbers’ brains and found that shifts in how blood moves through key arteries may hold the answer to acute mountain sickness.
Just Five Minutes Of Light Exercise Boosts Children’s Brain Power And Mood
As children worldwide spend more time seated and less time active, Japanese researchers have discovered that even minimal amounts of physical activity can make a significant impact.
A Molecular “Blocker” In The Brain May Hold The Key To Treating Depression
Korean researchers have found a protein called Numb that may block the brain’s natural antidepressant response, especially in older patients.
This RNA Protein May Help Slow Down Ageing
The study reveals that PELOTA-mediated RNA surveillance links ribosome quality control to longevity through autophagy regulation.
Filipino Researchers Decode A Rare Weather Mystery
The study mapped nearly two decades of hail events in the Philippines, revealing that these icy storms, although rare, are more widespread than previously believed.
Not Everyone’s Liver Reacts the Same to Alcohol—Here’s Why
In some people liver cells damaged by alcohol produce more reactive oxygen species, which can lead to cell death and trigger inflammation.
Scientists Identify Immune Cells That Unlock Scleroderma Mysteries
High levels of certain immune cells in patients with systemic sclerosis are linked to serious health problems, including scleroderma renal crisis and interstitial lung disease.
Youth Report Social Media Usage Impacting Their Self Worth And Mental Health
68 percent of the respondents reported difficulties with focusing, and 52 percent admitted they frequently got distracted by social media during their class at school.
“Pop The Biofilm” Treatment For Antibiotic-Resistant Superbugs
This new approach utilizes nanotechnology, gene suppression, and delivery strategies to combat superbug infections that antibiotics cannot treat.
Why High Altitudes Trigger Headaches
At the summit of Mount Fuji, researchers tracked blood flow in climbers’ brains and found that shifts in how blood moves through key arteries may hold the answer to acute mountain sickness.
Just Five Minutes Of Light Exercise Boosts Children’s Brain Power And Mood
As children worldwide spend more time seated and less time active, Japanese researchers have discovered that even minimal amounts of physical activity can make a significant impact.
A Molecular “Blocker” In The Brain May Hold The Key To Treating Depression
Korean researchers have found a protein called Numb that may block the brain’s natural antidepressant response, especially in older patients.
This RNA Protein May Help Slow Down Ageing
The study reveals that PELOTA-mediated RNA surveillance links ribosome quality control to longevity through autophagy regulation.
Filipino Researchers Decode A Rare Weather Mystery
The study mapped nearly two decades of hail events in the Philippines, revealing that these icy storms, although rare, are more widespread than previously believed.
Not Everyone’s Liver Reacts the Same to Alcohol—Here’s Why
In some people liver cells damaged by alcohol produce more reactive oxygen species, which can lead to cell death and trigger inflammation.
Scientists Identify Immune Cells That Unlock Scleroderma Mysteries
High levels of certain immune cells in patients with systemic sclerosis are linked to serious health problems, including scleroderma renal crisis and interstitial lung disease.
Youth Report Social Media Usage Impacting Their Self Worth And Mental Health
68 percent of the respondents reported difficulties with focusing, and 52 percent admitted they frequently got distracted by social media during their class at school.
“Pop The Biofilm” Treatment For Antibiotic-Resistant Superbugs
This new approach utilizes nanotechnology, gene suppression, and delivery strategies to combat superbug infections that antibiotics cannot treat.